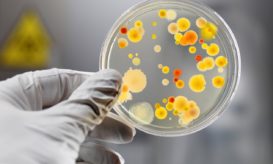

Νέα επικίνδυνο ανθεκτικό μικρόβιο βρέθηκε στα ελληνικά νοσοκομεία – Καμπανάκι από το ECDC
Τι ανακάλυψαν οι επιστήμονες αναλύοντας δείγματα του 2019 από 323 νοσοκομεία σε 36 ευρωπαϊκές χώρες.

Τι ανακάλυψαν οι επιστήμονες αναλύοντας δείγματα του 2019 από 323 νοσοκομεία σε 36 ευρωπαϊκές χώρες.

Γ. Πατούλης: «Η μικροβιακή αντοχή αποτελεί μια από τις μεγαλύτερες απειλές για τη δημόσια υγεία»

Το ένα είναι ανθεκτικό σε σχεδόν όλα τα υπάρχοντα αντιβιοτικά, το δεύτερο υπήρχε έως πρότινος μόνο στην Ινδία.

Χωρίς “όπλα” απέναντι στα πολυανθεκτικά μικρόβια είναι οι επιστήμονες στην Ελλάδα. “Χάνουμε άδικα ασθενείς”, λέει ο Καθηγητής Σύψας.
Η αντοχή των μικροβίων (βακτηρίων) στα αντιβιοτικά είναι μία από τις μεγαλύτερες απειλές για τη δημόσια υγεία.

Αύξηση λοιμώξεων και θανάτων λόγω μικροβιακής αντοχής στα ελληνικά νοσοκομεία, βάζει την Ελλάδα στην πρώτη θέση στην Ευρώπη για...

Στη σοβαρή διάσταση του φαινομένου της αντίστασης των μικροβίων στα αντιβιοτικά, αναφέρθηκε ο Καθηγητής Μικροβιολογίας, Αθανάσιος Τσακρής.

Η όλη έρευνα βρίσκεται σε αρχικά στάδια, αλλά δημιουργεί ελπίδες για την ανάπτυξη νέων αντιμικροβιακών θεραπειών.

Στο φως της δημοσιότητας βρέθηκε πρόσφατα ο πολυανθεκτικός -φονικός για τον άνθρωπο- μύκητας Candida auris, ο οποίος ενδημεί στα...

Με την φράση: «Τα επόμενα μεγάλα πρωτοσέλιδα όταν θα τελειώσει η πανδημία θα είναι τα πολυανθεκτικά μικρόβια στα νοσοκομεία», ο Καθηγητής...

Τη συμμόρφωση των γιατρών και των πολιτών στον νέο νόμο για την υποχρεωτική συνταγογράφηση των αντιβιοτικών εφιστά η Ένωση...

Απάντηση σε ΚΕΕΛΠΝΟ και Υπουργείο Υγείας για τους 1.627 νεκρούς κάθε χρόνο από πολυανθεκτικά μικρόβια, δίνει σήμερα με ανακοίνωσή...

Η Ελλάδα και η Ιταλία είναι οι δύο χώρες του ΟΟΣΑ όπου το πρόβλημα της ανθεκτικότητας των μικροβίων στα...

Ο ΙΣΑ ζητεί από το υπουργείο Υγείας να διευκρινίσει εάν το Κεντρικό Εργαστήριο Δημόσιας Υγείας διενεργεί τους ελέγχους στα...

Στην ειδική έκδοση του ΣΕΒ με θέμα το φάρμακο, προτείνεται να διασφαλιστεί από την μία πλευρά η πρόσβαση των...